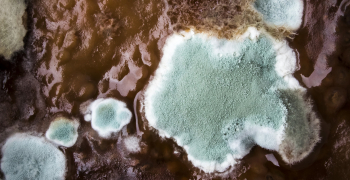

RIA Restoration Blog
Restoration & Remediation (11/07/19) Chris McQueen
Business Insurance (11/07/19) Matthew Lerner
Restoration & Remediation (11/06/19) Halden Shane
Reuters (11/14/19) Robert Birsel; Riccardo Bastianello; Colin Packham; et al.
Restoration & Remediation (11/14/19) Courtney Folk
Month after month, the AGA Committee's movement gains momentum in a way that is unprecedented in the property repair industry.
Restoration firms have the tools and the staff necessary to clean up after disasters strike, but they also can provide mold remediation and biological cleanup.
RIA believes this position statement is important in clarifying some of the steps toward resolution of this type of issue and in reducing the chance it will recur.